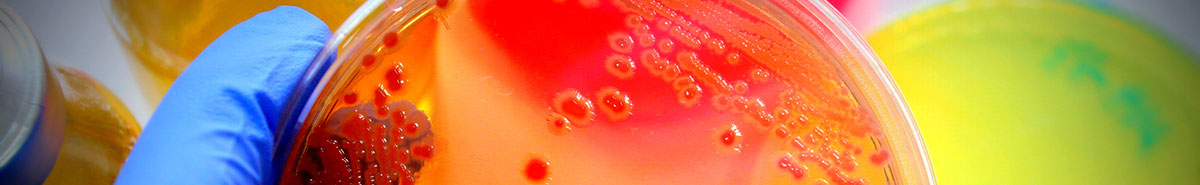

Labs
Labs
- Child Health Equity and Decision-making Research (CHEDR) — Developing, testing, and implementing interventions to address health and health care disparities
- Childhood Adversity and Resilience Lab — Research and interventions to improve outcomes associated with childhood adversity and trauma
- Dean Lab — Gene Therapy
- Dylag Lab — Investigates the mechanisms by which early-life respiratory exposures, such as oxygen and mechanical ventilation, shape lung development and long-term respiratory outcomes in premature infants
- Fazal Lab — Pathogenesis of Acute Lung Injury (ALI) and Acute Respiratory Distress Syndrome (ARDS), a life threatening pulmonary inflammatory condition
- Frey Lab— Evidence-based strategies for supporting patients and families managing asthma and chronic childhood illnesses
- Halterman, Jill Lab — The Preventive Care Program for Urban Children with Asthma
- Immunization Lab — Working toward a world that is free of vaccine-preventable disease
- Järvinen-Seppo Lab — Pre and postnatal development of immune system, the microbiome composition, and allergic diseases in farming and urban lifestyle infants. Human milk composition of immunologically active factors.
- Mariani Lab — Systems Biology of Lung Development and Disease
- McGraw Lab — Understanding the mechanisms of fibrotic lung disease in order to bring new therapies to people who suffer from this devastating disease.
- Mezu-Ndubuisi Lab — Developmental Origins, Mechanisms and Therapies for Retinopathy of Prematurity
- Michmerhuizen Lab — Seeks to understand the molecular mechanisms underlying fusion oncoprotein-driven cancers, and in doing so identify novel strategies to improve patient outcomes
- O'Reilly Lab — Developmental Origins of Lung Disease
- Palis Lab — Ontogeny of Hematopoiesis; Erythroid Differentiation; Erythroid Precursor Self-Renewal; Hematopoiesis-Response to Radiation
- Pryhuber Lab — Inflammatory Neonatal Lung Injury
- A. Rahman Lab — Mechanistic Targets in Acute Lung Injury
- Rowe Lab — Intersection of Viruses and Allergic Disease
- Scheible Lab — Systems immunology approach to understanding molecular mechanisms and clinical outcomes related to early immune development in human infants
- Steiner Lab — Molecular mechanisms underlying the development of red blood cells
- Young Lab — Bioactive components in human milk (such as hormones and growth factors) differ by maternal characteristics